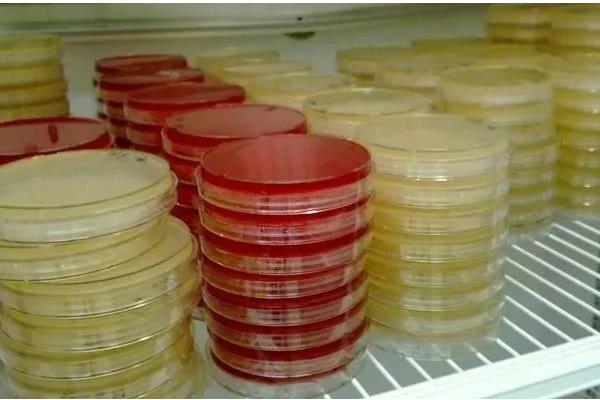
怎么养殖灵芝，把温度保持在22-28℃

1、配制培养基:使用木屑、米糠、玉米芯、稻草、棉壳配制培养基。
2、环境要求:生长适温22-28℃,菌丝生长期空气相对湿度为60-70%,子实体生长期空气相对湿度为85-90%。
3、良好通风:种植过程中,注意加强环境通风。制作菌棒时需封口,菌丝长满菌袋后,于两头扎微孔通风透气。
4、注意事项:采摘灵芝时,使用枝剪进行采摘,切忌用手直接掰。

一、怎么养殖灵芝
1、配制培养基
灵芝是一种腐生菌,对木质素、纤维素、半纤维素等具有较强的分解吸收能力,因此养殖时,可以选用木屑、米糠、玉米芯、稻草、棉壳等混合配制培养基。

2、环境要求
养殖灵芝时要求空气相对湿度,在菌丝生长阶段为百分之六十到七十,子实体生长期为百分之八十五到九十,此外灵芝属于高温型真菌,要求生长温度保持在二十二到二十八度。
3、良好通风
灵芝是一种好气性真菌,在培养灵芝的过程中,一定要注意通风环境,灵芝菌棒制作时,最好使用塑料和棉塞封口,等菌丝长满菌袋后,必须将菌袋两头扎微孔进行通风透气。

4、注意事项
成熟的灵芝通常都呈木质化或角质化,并且与菌柄和培养基紧密连接,若是直接用手掰下子实体,容易损伤菌筒,不利于潮芝的生长,伤口也易被病菌感染,因此在采摘时要使用枝剪。

二、怎么养活体灵芝盆景
1、温暖的环境
活体灵芝盆景在生长期间对环境温度的要求较高,日常养护时,需将室温控制在25-28℃之间,若温度长期低于25℃,会使使得植株的生长速度变慢,皮壳色泽也会变差。当气温高于35℃时,还需经常往叶片周围喷水降温。

2、遮光防晒
日常养护活灵芝盆景的过程中,还需保持好光线的照射,在光线偏弱的环境下植株才可以生长的更为旺盛,因而在日常养护时需遮挡住80%的光照,以维持植株的正常生长。若长期接受强光暴晒,会使得植株出现生长不良的状况。

3、浇水方式
灵芝适宜生长在湿润的环境中,在养殖期间,每天需浇一次水,确保土壤处于湿润的生长状态。浇水时需选择纯净水或静置后的自来水。并且在夏季浇水时,需选择在气温较低的清晨或傍晚进行,以维持植株的正常生长。

4、定期清洁
注意在养殖活体灵芝盆景的过程中,需保证主体表面的清洁。灵芝在生长过程中会通过叶片进行呼吸,若表面附着大量灰尘,会使得植株出现生长不良的状况,因而需每隔3-4天试用湿毛巾擦拭一次叶片。

声明:本文由作者上传并发布,农服务网仅提供信息发布平台,文章仅代表作者个人观点,不代表农服务网立场,内容旨在传播知识,若有内容错误或侵权等问题请及时与本网站联系,我们将在第一时间作更正或删除处理。